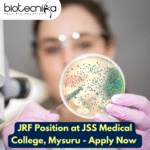
Pfizer Project JRF Position at JSS Medical College, Mysuru – Apply Now JRF Position at JSS Medical College, Mysuru - Apply Now

Home Search
microbiology - search results
If you're not happy with the results, please do another search
Pfizer Project JRF Position at JSS Medical College, Mysuru – Apply Now
JRF Position at JSS Medical College, Mysuru - Review the information provided below and Apply now
Application invited from eligible candidate for the post of...
Biotecnika Times Newsletter 05.09.2023 IIT JAM 2024 Registrations Open, Freshers MSc Biotech, Biochem Job,...
Biotecnika Times Newsletter IIT JAM 2024 Registrations Open, Freshers MSc Biotech, Biochem Job, BSV Jobs, IISc Hands-on Training, Bioinformatics Internship + Much More
IIT JAM...
ACTREC BSc Life Sciences Project Assistant Job – Attend Walk-In-Interview
ACTREC BSc Life Sciences Project Assistant Job - Attend Walk-In-Interview
ACTREC BSc Life Sciences Project Assistant Job - Attend Walk-In-Interview. Walk-in-Interview For B.Sc Life Science,...
JRF Opening at RCB – MSc Life Science Candidates Apply Online
Regional Centre for Biotechnology, Faridabad JRF Opening. Life Science MSc Job. Please go through the details and apply online.
This job expires in
This job has...
ACTREC MSc Vacancy Project JRF/SRF Life Sciences Job Opening – Attend Walk-In-Interview
ACTREC MSc Vacancy Project JRF/SRF Life Sciences- Attend Walk-In
ACTREC MSc Vacancy Project JRF/SRF Life Sciences- Attend Walk-In. Junior Research Fellow or Senior Research Fellow...
Biotecnika Times Newsletter 04.09.2023 BIRAC High Paying Jobs, Got NCT of Delhi Hiring, NIPER...
Biotecnika Times Newsletter 04.09.2023 BIRAC High Paying Jobs, Got NCT of Delhi Hiring, NIPER Jobs, Bioinformatics Internship + Much More
BIRAC Life Sciences & Biotech...
Applications Invited For The Position of SRF at ICMR-NIIH – Apply Now
ICMR-NIIH SRF Job For MSc Bioinformatics, Biology, Life Sciences - Apply Online
ICMR-NIIH SRF Job For MSc Bioinformatics, Biology, Life Sciences - Apply Online. Applications...
Panjab University MSc & MTech Life Sciences Research/Project Assistant Jobs
Panjab University MSc & MTech Life Sciences Research/Project Assistant Jobs
Panjab University MSc & MTech Life Sciences Research/Project Assistant Jobs. Research Assistant and Project Assistant....
Yenepoya (Deemed To Be University) MSc (By Research) On Computational Biology and Bioinformatics &...
Yenepoya Admissions 2023-25 Open For MSc (By Research) On Computational Biology and Bioinformatics & MSc Bioscience
MSc (by Research) on Computational Biology & Bioinformatics
Yenepoya (Deemed...
MSc Jobs at Thermo Fisher – Life Sciences Apply Online For Production Lead Role
MSc Jobs at Thermo Fisher - Life Sciences Apply Online For Production Lead Role
MSc Jobs at Thermo Fisher - Life Sciences Apply Online For...
Biotecnika Times Newsletter 01.09.2023 IISc Postdoc Post, Final Registrations, Hersheys QA Job + Much...
Biotecnika Times Newsletter 01.09.2023 IISc Postdoc Post, Final Registrations, Hersheys QA Job + Much More For National Workshop,
Apply for the C V Raman...
Apply for the C V Raman Post-Doctoral Position and the Institution of Eminence Post-Doctoral...
IISc Post Doc Post - Apply for the C V Raman Post-Doctoral Position
Indian Institute of Science
Bangalore – 560 012
Apply for C V Raman and/or...
Hershey Executive QA Post For Food Technology Candidates – Apply Online
Hershey Executive QA Post for Food Technology Candidates - Apply Online
Hershey Executive QA Post for Food Technology Candidates - Apply Online. Latest Hershey Executive...
Biotecnika Times Newsletter 31.08.2023 – C-CAMP Hiring, GATE 2024 Application Portal Open, Biotech Internship,...
Biotecnika Times Newsletter 31.08.2023 - C-CAMP Hiring, GATE 2024 Application Portal Open, Biotech Internship, Bioinformatics Internship, IISc Hands-on Training, Syngene Ramaiah Certificate Program +...
International Conference on Recent Innovations in Biotechnology 2023 (I-CRIB) at Sathyabama
I-CRIB 2023 at Sathyabama - Registrations Open
International Conference on
Recent Innovations in Biotechnology
Thursday 21st September to Saturday 23rd September 2023
In Hybrid Mode
(Online & Offline)
Important Dates
...